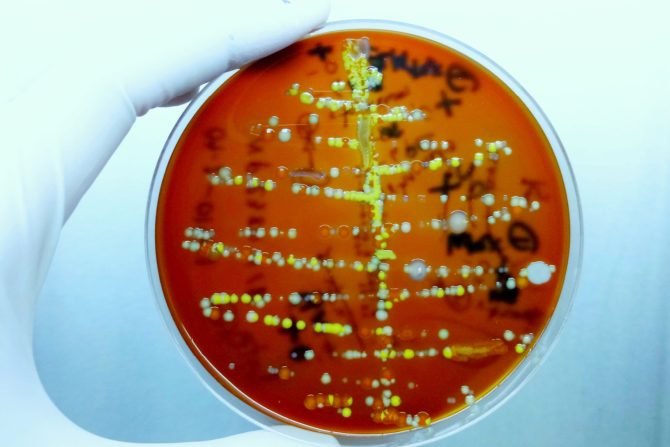
antibiotik

Kako deluje novi antibiotik odobren za lečenje urinarnih infekcija kod žena
Prednost novog leka i prevazilaženje rezistentnosti na antibiotike, jednog od najvećih problema u lečenju infekcija
Američka agencija za hranu i lekove (Food and Drug Administration/FDA) prvi put je u poslednjih 20 godina odobrila novi lek za infekcija urinarnog trakta (UTI) kod žena. Reč je o oralnom antibiotiku pod nazivom Pivia, namenjenom lečenju blažih oblika ovih čestih infekcija.
Kako deluje novi antibiotik
Vest je izuzetno značajna budući da se posle dve decenije konačno pojavio medikament odobren za lečenje lakših, nekomplikovanih infekcija urinarnog trakta kod žena. Lek Pivia (pivmecillinam) tako postaje dragocen novi metod u kliničkom lečenju čestih infekcija, koje su sve rezistentnije na postojeće antibiotike. Upravo to je njegova možda i najvažnija prednost. Naime, trebalo bi da osobe koje ga koriste imaju manju šansu da razviju otpornost na antibiotike u poređenju sa drugim tretmanima za ovaj zdravstveni problem.
Pivia je sintetička verzija penicilina koja može da leči urinarne infekcije uzrokovane nekim od najčešćih bakterija koje izazivaju UTI. Koristi se kao tretman prve linije lečenja u Kanadi i delovima Evrope više od 40 godina.
Naučnici o urinarnim infekcijama i tome koje koristi donosi odobreni antibiotik
Statistika kaža da otprilike polovina svih žena dobije barem jednu urinarnu infekciju u sživotu, a približno četvrtina žena pati od recidivnih, ponavljajućih oblika.
- Nekomplikovane urinarne infekcije, odnosno infekcije u blažoj formi su veoma često stanje koje pogađa žene i jedan od najčešćih razloga za upotrebu antibiotika - kaže je dr Peter Kim, direktor Odeljenja za antiinfektivne lekove u Centru za procenu i istraživanje lekova FDA (Division of Anti-Infectives in the FDA’s Center for Drug Evaluation and Research).
Pojašnjavajući pojam "nekomplikovane UTI", dr Sarah McAchran, urolog, uroginekolog i vanredni profesor na Univerzitetu u Viskonsinu navodi da se one javljaju kod osoba koje nemaju poznate faktore rizika koji bi ih učinili posebno podložnim razvoju hroničnih oblika. Dr McAchran ovu novu mogućnost lečenja smatra fantastičnom. Takođe je mišljenja da bi trebalo da rezultira manjom otpornošću na antibiotike u odnosu na neke druge koje lekari koriste za lečenje rekurentnih infekcija urinarnog trakta.
Na koje bakterije posebno efikasno deluje novi antibiotik
Prema rečima stručnjaka i zaključcima ove studije, antibiotik Pivia može da neutrališe tri najčešće vrste bakterija koje izazivaju UTI: Escherichia coli, Proteus mirabilis ili Staphilococcus saprophiticus. Inače, E. coli je najčešći uzročnik urinarnih infekcija. Mnogi uobičajeni antibiotici postali su manje efikasni u lečenju UTI poslednjih godina jer su bakterije koje ih izazivaju postale otpornije na lečenje.
FDA savetuje da se ne propisuju antibiotici ako ne postoje dokazi da su simptomi uzrokovani bakterijskom infekcijom, jer njihova primena ne može da izleči stanje, a potencijalno povećava rezistenciju na antibiotike. Uprkos tome, prema izveštaju Svetske zdravstvene organizacije iz 2022. godine, više od jednog od ukupno pet uzoraka urina koji sadrži E. coli bilo je otporno na antibiotike prve i druge linije lečenja. U studiji iz 2019. godine, čak 80 odsto uzoraka urina bilo je rezistentno na najmanje dva uobičajena antibiotika.
Efikasnost leka i neželjeni efekti
Klinička ispitivanja pivmecilinama datiraju još iz sedamdesetih godina prošlog veka. FDA je dala odobrenje na osnovu tri klinička ispitivanja kako bi se videlo koji režim doziranja je najbolje funkcionisao i da li je bilo boljeg učinka od drugih uobičajenih antibiotika. Kod više od 60 odsto pacijenata koji su primili ovaj antibiotik primećen je nestanak simptoma. Nije bilo ni novih znakova infekcije u periodu od dve nedelje nakon uzimanja leka, u poređenju sa 10 odsto onih koji su uzimali placebo. U odnosu na druge oralne antibiotike, oporavilo se 72 procenta onih koji su uzimali novi lek.
Najčešći neželjeni efekti uključuju mučninu i dijareju, saopštila je FDA. Data je i preporuka da ljudi sa ozbiljnom preosetljivošću na beta-laktamske antibakterijske lekove poput penicilina ne bi trebalo da uzimaju Piviu. Ostale kontraindikacije uključuju veoma retke metaboličke poremećaje.
eKlinika zadržava sva prava nad sadržajem. Za preuzimanje sadržaja pogledajte uputstva na stranici Uslovi korišćenja.


Dragana N
Mene zanina kako ovaj lek deluje na druge, korisne bakterije, da li i njih unistava?
Podelite komentar